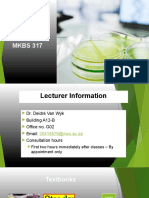

1/21/2021
Lecture 03
Implementing NEQS”
Pakistan’s Experience in
Industrial Pollution
Control
Subject: Environmental Engineering I
Section: Introduction to Environmental
Engineering
Implementing NEQS”
Pakistan’s Experience in
Industrial Pollution Control
Disclaimer: the material used in this presentation i.e., pictures/graphs/text, etc. is solely intended for
educational/teaching purpose, offered free of cost to the students for use under special circumstances of
Online Education due to COVID-19 Lockdown situation and may include copyrighted material - the use of
which may not have been specifically authorised by Copyright Owners. It’s application constitutes Fair Use
of any such copyrighted material as provided in globally accepted law of many countries. The contents of
presentations are intended only for the attendees of the class being conducted by the presenter.
.
1
� 1/21/2021
After completion of this class discussion
the students will be able to:
Describe history and need of NEQS
Enlist modalities of NEQS
Outlines
Glossary
Introduction
Environmental Quality Standards (Selected Parameters)
for 10 Asian Countries
The Negotiation Process
Members of the Committee
The Mandate of the Environmental Standards Committee
Review of National Environmental Quality Standards
Concept of Pollution Charge
Formula for Pollution Charge Calculations
Mode of Collection and Use of Funds
Use of Pollution Charge
Financial Incentives for Industry
Recommendations for future action
2
� 1/21/2021
Glossary
APTMA All Pakistan Textile Processing Mills Association
DFI Development Finance Institution
EPA Environmental Protection Agency
ESC Environmental Standards Committee
ETPI Environmental Technology Programme for Industry
FPCCI Federation of Pakistan Chambers of Commerce and Industry
IUCN The Word Conservation Union
NDFC National Development Finance Corporation
NEQS National Environmental Quality Standards
NGOs Non-Governmental Organizations
OCAC Oil Companies Advisory Committee
OICCI Overseas Investors Chamber of Commerce and Industry
PEPC Pakistan Environmental Protection Council
PETFs Provincial Environmental Trust Funds
PSDFs Provincial Sustainable Development Funds
SDPI Sustainable Development Policy Institute
TTSID Technology Transfer for Sustainable Industrial Development
Introduction
A pollution charge regime is being introduced in Pakistan as a
measure to achieve industrial compliance with the National
Environmental Quality Standards (NEQS).
The modalities for the implementation of the pollution charges
have gone through a unique consultative process between
representatives of industry, government, environmental NGOs
and academic researchers.
The consensus of all stakeholders has been to adopt a market
based approach, i.e., a pollution charge or tax combined with
fiscal incentives to industries, rather than a use of coerce
criminal procedures for ensuring compliance with NEQS.
3
� 1/21/2021
Introduction
Although originally promulgated by the government in 1983, there
had never been a concentrated effort to implement the NEQS until
the Pakistan Environmental Protection Council (PEPC) was
reactivated in 1993 by Mr. Asif Ali Zardari, the Minister for
Environment.
The Sustainable Development Policy Institute (SDPI) suggested the
use of a pollution charge1, based on the German experience in
pollution control.
Environmental Quality Standards (Selected
Parameters) For 10 Asian Countries
4
� 1/21/2021
Problems to comply with new environmental
standards
There are obvious obstacles in the transition to more sustainable industrial
production, not least of which is the excessive cost of new technology, lack of
technical know-how or expertise, insufficient credit availability, and the already
weak financial health of the industrial sector.
Faced with these problems, it has been a challenging task to convince industry,
especially the non-exporting sectors, to comply with new environmental
standards.
The Negotiation Process
In order to rationalize the NEQS and to work out detailed
modalities for their implementation, PEPC constituted (12
March 1996) the Environmental Standards Committee
(ESC) under the chairmanship of Dr. Shamsh Kassim-
Lakha, President of The Aga Khan University, and
designated SDPI as its Secretariat.
10
5
� 1/21/2021
Members of the Committee
The members of the Committee included
representatives from the Ministry of Environment,
Federal and Provincial Environmental Protection
Agencies (EPAs), public and private sector
corporations, industrial chambers and associations,
environmental NGOs, research organizations, and
legal experts.
11
The Mandate of the Environmental Standards
Committee (ESC)
The mandate of the ESC was very specific: “to review the NEQS and
suggest changes where necessary, and to recommend modalities for
enforcing them”.
But in order to accomplish this mandate a multi-dimensional strategy
would be necessary – one that combined a creative market-based
formula with technical support to the industry and government, a
mass awareness programme and an effective monitoring system.
And the only way to ensure success was to do it openly and
transparently.
12
6
� 1/21/2021
Review of National Environmental
Quality Standards
Negotiations began with a review of the NEQS
themselves.
Considerable objections were raised by the private sector
that these had not been developed through public
consultation and, therefore, some of the standards were
unrealistic.
A technical committee was formed to address specific
objections against each of the parameters in question.
13
Concept of Pollution Charge
The concept of the pollution charge is a key element of the
implementation program.
As mentioned before, it was introduced after extensive discussions
with businesses, government, and the private industrial sector, in
response to worries that the NEQS should not be enforced on
existing industrial units through forced criminal procedures.
According to the present proposal, the charge would be calculated
on the basis of a pollution load measured in pollution units 5
14
7
� 1/21/2021
15
16
8
� 1/21/2021
Formula for Pollution Charge Calculations
A number of proposals were reviewed extensively for
determination of pollution charges.
(i) The proposal should be an equitable, simple, and
workable approach towards establishment of
pollution charges.
(ii) It will ensure real progress towards making the
industry environmentally friendly without put in
danger the economic growth in the country.
(iii) Industry should be allowed sufficient time in
which to prepare for compliance with NEQS.
17
Formula for Pollution Charge Calculations
The initial proposal submitted by SDPI recommended
linking the pollution charge to the cost of effluent cleanup.
Another variation of this proposal suggested linking it to
the cost of environmental damage caused.
In either case, a gradual increase was recommended so
that industry would be induced to adopt cleaner production
methods and technology over time.
18
9
� 1/21/2021
Formula for Pollution Charge Calculations
The proposal on which consensus was finally reached was
developed jointly by SDPI, the Federal EPA and Halger Bailly
Pakistan.
Based on the experience in Germany with the use of pollution
charges, this program will levy pollution charges on the basis of
pollution units.
19
Formula for Pollution Charge Calculations
It took weeks of negotiations amongst industry representatives to
establish both a pollution charge and a progressive escalation
schedule.
This was an unprecedented achievement in Pakistan and perhaps
also elsewhere in the world where industry voluntarily agreed to a
charge to be applied to themselves for generating pollution in excess
of permissible national limits.
The FPCCI task force also recommended that the pollution charge
be renamed to Environmental Improvement Charge.
20
10
� 1/21/2021
Mode of Collection and Use of Funds
It was agreed that the money collected as pollution charges
would be made available for environmental services to benefit
industry (see Box 1), the private sector has been inflexible that
these funds must not be deposited into the national treasury
from where they are likely to be utilized for other purposes.
Instead, they have strongly advocated the creation of Provincial
Environmental Trust Funds (PETFs) that
would be governed by a tripartite board of private sector,
government and NGO representatives.
21
Use of Pollution Charge
Money collected will be used primarily for activities that will help in
reduction of environmental pollution through the following
activities:
Provision of soft loans for the purchase of pollution treatment
equipment.
Installation of combined effluent treatment plants in industrial
estates.
Research and analysis in support of pollution abatement.
Round tables, conferences, workshops for pollution abatement.
Provision of incentives to develop indigenous technology for
pollution control.
Training and advisory services for industry.
22
11
� 1/21/2021
Financial Incentives for Industry
Following extensive negotiations with the
government in the ESC, the Pakistan
Environmental Protection Council approved a
detailed proposal for provision of fiscal (financial)
incentives to industry for pollution abatement or
compliance with NEQS.
23
Financial Incentives for Industry
24
12
� 1/21/2021
Financial Incentives for Industry
25
Recommendations for future action
Institutionalizing government-business dialogue
Need for public pressure
Enforcement of existing and agreed pollution prevention
regulations
Technical Assistance
Elimination of perverse (awkward) subsidies
Green cash required
26
13
� 1/21/2021
27
14